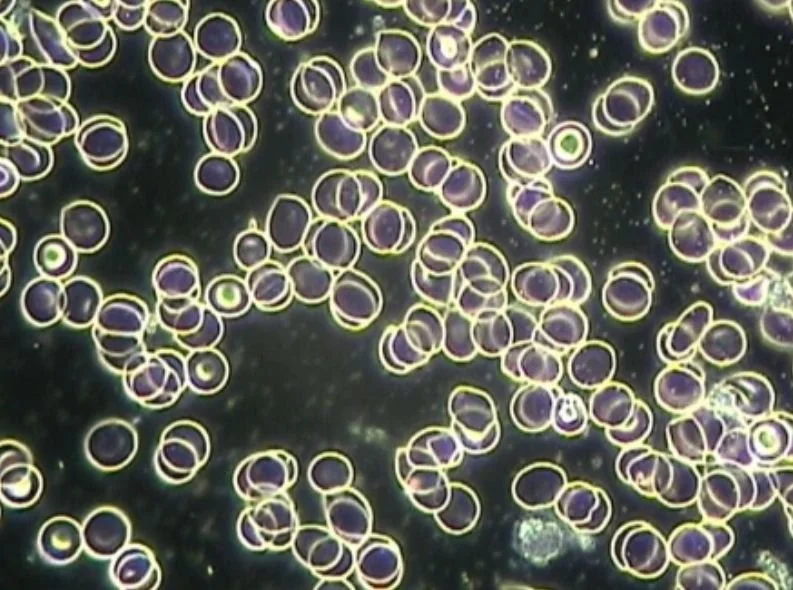

Research
Each piece of Golden Spirit Jewelry is thoughtfully handcrafted using high-quality materials, with symbolism and design elements that reflect intention, meaning, and artistry.
Once created, each necklace is energetically refined using Leela Quantum Tech’s Quantum Bloc technology, adding an additional layer designed to support coherence and balance within the body’s energy field.
At the intersection of science and subtle energy, Leela Quantum Tech explores how frequency and coherence may interact with the body’s natural systems. Across a growing body of third-party studies, including randomized, placebo-controlled, and double-blind research designs, independent institutes, doctors, and laboratories have examined reported findings related to heart rate variability (HRV), brainwave activity, cellular function, and energetic coherence. Independent assessments reported on leelaq.com suggest measurable shifts associated with balance, clarity, and overall energetic harmony in a non-invasive way.
Research and observational studies have incorporated a range of analytical tools, including EEG brainwave analysis, Bio-Well imaging, live blood analysis, water crystallography, ATP assays, and microscopy. While this emerging field continues to evolve, the ongoing research reflects a commitment to transparency, third-party validation, and a deeper exploration into how frequency and subtle energy may influence everyday well-being.
Golden Spirit Jewelry and Leela Quantum Tech products are intended for educational and wellness purposes only and are not intended to diagnose, treat, cure, or prevent any disease.




Study Design & Methodology
Leela Quantum Tech’s technology is supported by a growing body of research conducted by independent institutes, doctors, and laboratories around the world. Using established scientific methodologies, including randomized, placebo-controlled, and blinded study designs, researchers are exploring how frequency-based technology may interact with biological systems, environmental coherence, and overall well-being.
Third-party organizations and research groups, including the BESA Institute, BION Institute, Emoto Institute, and researchers affiliated with the University of Tulsa, have participated in studies examining reported effects related to coherence, balance, and energetic environments. While this field continues to evolve, the ongoing research reflects a commitment to transparency, third-party validation, and deeper exploration into the role subtle energy may play in everyday life.
A range of analytical tools and observational methods have been used throughout these studies, including heart rate variability (HRV), EEG brainwave analysis, Bio-Well imaging, live blood analysis, water crystallography, ATP assays, and microscopy. Reported findings from these studies suggest measurable shifts related to stress response, energetic coherence, and the body’s natural systems, though research in this emerging field is still developing and continues to be explored.
Randomized
Placebo-Controlled
Blinded Study Design
Third-Party Research
Disclaimer: These statements have not been evaluated by the Food and Drug Administration. The products are not intended to diagnose, treat, cure, or prevent any diseases.
Featured Study 1 of 5
Brainwaves and HRV: What Is the Impact of Quantum Energy on EEG and Heart Rate Variability (HRV) During 5G Exposure?
Randomized study by German Foundation for Health Information and Prevention
When quantum technology was activated, the study reported measurable shifts in brainwave activity and heart rate variability (HRV), including:
77.6%↓
Gamma activity in the limbic system was reduced by 77.6% (commonly associated with heightened stress and stimulation)
82.9%↓
Beta activity in the temporal lobe decreased by 82.9% (often linked to active thinking and stress responses)
13x↑
Alpha activity increased more than 13-fold (commonly associated with relaxed, calm states)
HRV↑
HRV parameters showed significant changes, returning toward baseline levels (HRV is commonly used as an indicator of the body’s adaptability and resilience)
These findings point to a potential relationship between quantum technology and changes in neurological and cardiovascular patterns during 5G exposure, offering a promising area for continued research.
Featured Study 2 of 5
Impact of Quantum Energy on Cellular ATP Production: Can Quantum Energy Influence Energy Metabolism at the Cellular Level?
Double-blind study by Dr. Robert Sheaff, USA
Preliminary lab studies indicate that Leela Quantum Tech’s field-based technology may support increased cellular energy output. In controlled double-blind experiments, cells exposed to the technology demonstrated up to 29% higher ATP levels, the primary energy currency of the cell, compared to unexposed cells.
29%↑
Up to 29% higher ATP levels observed
(ATP is the primary energy currency of the cell, supporting essential cellular activity.)
Featured Study 3 of 5
Leela Quantum Bloc and Wi-Fi Radiation: Does It Provide Protection Against Adverse Effects?
Randomized, single-blinded, and sham-controlled study by Dr. Beverly Rubik, USA
The studies by Dr. Rubik evaluated the Leela Quantum Bloc’s protective effects on blood exposed to Wi-Fi radiation. Wi-Fi exposure increased red blood cell clumping and decreased white blood cell motility. The Quantum Bloc significantly reduced these adverse effects, suggesting its potential to protect blood from Wi-Fi radiation.
Baseline Blood Cells

Blood Cells with Wi-Fi Exposure

Blood Cells with Quantum Bloc Technology
Featured Study 4 of 5
Dark-Field Microscopy Study: Harmonization of Human Blood Parameters through Quantum Entanglement
Randomized and double-blinded study by BESA Institute in Austria
In this exploratory, randomized, double-blind study, researchers leveraged quantum entanglement to test the Infinity Bloc’s effectiveness. After just 15 minutes of exposure, blood samples revealed notable improvements, including:
Reduced erythrocyte agglutination (less clumping of red blood cells)
Normalization of fibrin structures, supporting optimal blood flow
A rapid harmonizing effect on hemodynamics, suggesting enhanced biological balance
Featured Study 5 of 5
Impact of Leela Quantum Tech on the Structure of Water
Study by Emoto Institute, Japan
Dr. Masaru Emoto was a Japanese Scientist who proved that our thoughts and intentions can affect physical matter through his experiments with water. He studied water and how it physically changes when exposed to human sound, thoughts, and intentions. Dr. Emoto found that water exposed to positive intentions would form more “perfect” crystals when frozen, and water exposed to negative intentions would form random crystals. Similarly, water from a clean, natural source will have more perfect crystals than a polluted water source. His legacy continues through his son, Hiro Emoto, and the Emoto Institute Japan. The Emoto Institute Japan tested Leela Quantum Tech to study and visualize their effect on water.
“The Leela Quantum Bloc improved the energy of water significantly within only 3 minutes. From only one beautiful crystal in the control water, the treated water then had five beautiful crystals.”

See All of Leela Quantum Tech’s Studies
Explore the full library of studies to learn more about the research behind Leela Quantum Tech’s technology. Their research spans a range of areas, from biological systems to environmental coherence, offering a deeper look into this emerging field.

As with many emerging technologies, understanding deepens through both research and lived experience. We invite you to experience it for yourself.
Experience it for yourself.
Newsletter
Be the first to know about our new collection launch.
